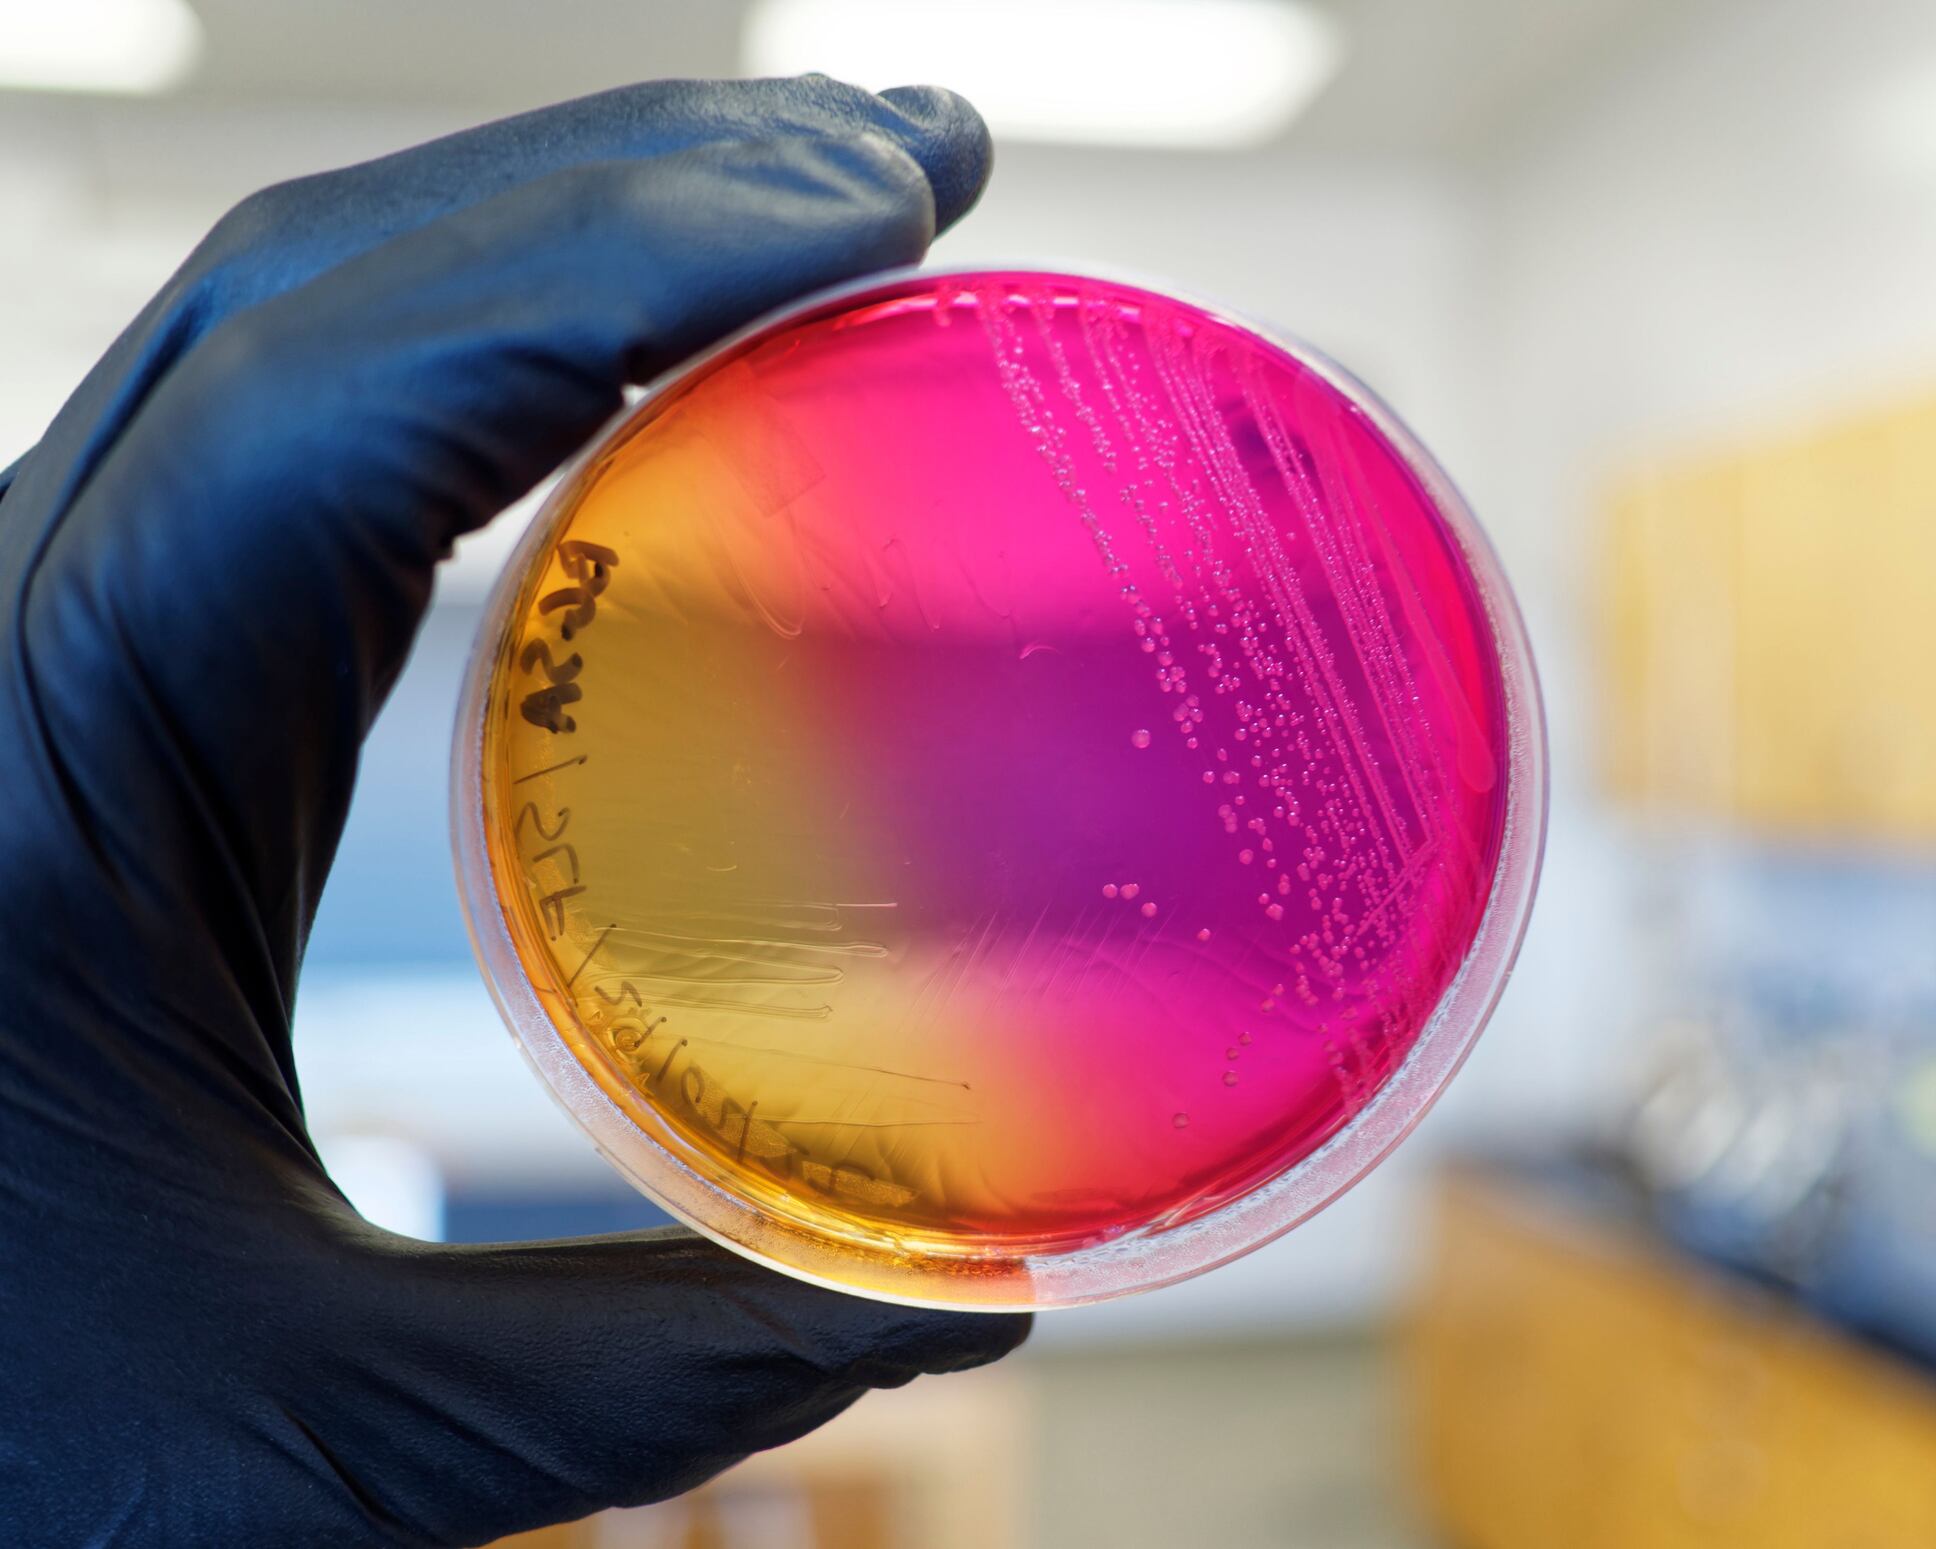

1. Big bacteria breakouts
The last year saw a number of big outbreaks related to both Salmonella and Listeria.
Continuing to wreak havoc from 2021, by 11 January 2022, 272 cases of Salmonella Enteritidis ST11 infections had been reported across five EU/European Economic Area countries and the UK.
The outbreak was linked to eggs and for the most part, pinpointed to France (216 cases), but the source remained a mystery.
In April, headlines changed to Listeria monocytogenes, as an ongoing outbreak in the UK was linked back to smoked fish. Organisms like Listeria can grow in all ready to eat foods that are vacuum packed but smoked, raw and cured fish products are particularly vulnerable to contamination.
Whole genome sequencing (WGS) analysis was used to identify the outbreak, which dated back to as early as 2020, with more than half of these (eight in 14) occurring since January 2022.
“While the risks to the general public of becoming seriously ill due to Listeria are very low, we need people who are vulnerable – specifically those over 65, pregnant women and people with weakened immune systems – to be aware of the ongoing risks of consuming ready to eat smoked fish,” said Dr Caroline Handford, Acting Head of Incidents for the Food Standards Agency (FSA).
In May, another notable case of Salmonella made the news, as meat processor Cranswick confirmed an outbreak at its poultry facility in Hull.
A limited number of cooked chicken products were identified as contaminated at the Benson Park site, which had been sold as ingredients for sandwiches and meals through various UK retailers and food-to-go outlets.
To reduce disruption, the manufacturer outsourced cooked poultry on a short-term basis. Whilst Pret A Manager, Sainsbury’s and Aldi recalled chicken products linked to the Hull factory.
Perhaps one of the most memorable cases of 2022, however, was the closure of the Belgium Ferrero factory, which was centre of a major Salmonella outbreak. In April, the company recalled selected batches of Kinder Surprise products following investigations led by UKHSA, Public Health Scotland, Public Health Wales and Public Health Agency Northern Ireland, which found a link between reported cases of Salmonella poisoning across the UK and a specific product produced by Ferrero in Arlon.
On the 8 April, authorisation for the factory was removed, with a conditional authorisation granted in June, which saw it restart its production lines. This reopening followed extensive cleaning and food safety controls conducted in close partnership with the Belgium food safety authority (AFSCA).
Commenting at the time, Ferrero Group’s Chief Executive Officer said: “We are truly sorry for what happened and would like to apologise once again to all those impacted. We have never experienced a situation like this in our 75-year history. We have taken learnings from this unfortunate event and will do everything to ensure it does not happen again.”
But as things started picking up for the Belgium-based Ferrero factory, just a month later, Barry Callebaut’s plant in Wieze suspended production as a result of Salmonella.
A statement from the manufacturer identified lecithin – an emulsifier used in chocolate production – as the source of the contamination.
Barry Callebaut confirmed that no Salmonella positive chocolate reached retail.
The first cleaned and disinfected products lines were reopened in August, marking an important milestone in its cleaning operation which was “unprecedented in scale” for the company, with the factory back in action fully by October 2022.
“Great to see our Wieze factory operational again!” Peter Boone, CEO, wrote on a Linked In post. “I would like to express my deepest gratitude to our customers for their understanding during this difficult period, and to all our employees who worked tirelessly for weeks to get the Wieze factory up and running again.”
2. Job losses
Whilst some factories saw temporary shutdowns due to contamination, other factories closed doors for good for a number of reasons, among them profitability.
Starting in September, Moy Park proposed the closure of its Ashbourne factory, which placed 900 jobs at risk. The decision was later reserved, with a reshape of its facility suggested instead. This was said to have saved 175 positions.
Commenting on the U-turn, Mick Coppin, GMB Organiser, said: “GMB has been negotiating and campaigning to save jobs at Moy Park for months. To see management sit up and listen to our members’ demands is fantastic.
“These workers are absolutely essential in producing and supplying our favourite chicken products across the country, in the home and in well love restaurant chains including Nando’s and McDonalds.
“Potential job losses on the scale feared would have been catastrophic for the local community.”
Unfortunately, for pork pie brand Vale of Mowbray, the outcome wasn’t so bright, as the organisation entered administration last September. Overall, 171 roles were made redundant.
The closure was said to be a consequence of significant financial challenges due to rising raw material input prices, increasing energy costs and sector-wide recruitment issues.
The following month, cake and baked goods manufacturer, BBF (Bright Blue Foods), announced its proposed shutdown of Sargents Bakeries.
The move came little over a year after BFF’s acquisition of the Doncaster-based company.
November brought with it another closure proposal, as fresh food manufacturer Bakkavor put forward the potential shutdown of two factories – Bakkavor Salads in Sutton Bridge, Lincolnshire and Bakkavor Desserts in Leicester.
Cost was flagged yet again as a key factor, with the company saying that it had been affected by inflation and consumer headwinds which it expected to continue into next year.
Then, in November, Pilgrims Food Masters announced the closure of its Southall factory on Collett Way, prompting a demonstration from its workers.
The company cited external market conditions that “continue to be extremely challenging” across the entire industry as the main reason.
3. Natasha’s Law becomes reality
October 2022 saw the long awaited - and fought for - introduction of Natasha’s Law. The new law covers England, Wales, Scotland and Northern Ireland and requires all food outlets to provide full ingredient lists with clean allergen labelling on pre-packaged for direct sale (PPDS) foods.
This followed the tragic death of Natasha Ednan-Laperouse, who suffered an allergic reaction to a baguette from Pret A Manager.
Prior to this ruling, food prepared on the premises it was sold upon did not require allergen information to be labelled on the packaging.
Commenting on the new law, then Food Minister Zac Goldsmith said: “This is a significant moment for the millions of allergy sufferers in England and a fitting tribute to Nadim and Tanya Ednan-Laperouse’s tireless campaigning.”
Adding to this, the family of Natasha Ednan-Laperouse said: “This is a hugely significant day for allergen sufferers in this country. The introduction of Natasha’s Law brings greater transparency about what people are buying and eating, lays down new standards for the food companies, and highlights the battle against the growing epidemic of allergies.”
4. Cybercrime rears ugly head
We’ve seen some momentous progression within technology, both inside and outside of the world of food and drink.
Connected and intelligent devices have the potential to solve many of the biggest challenges we’re seeing today, including food waste in the factory and even automated machine maintenance to ensure high productivity.
However, the more reliant we become on the digital world, the more likely we are to see spikes in cybercrime. Will this become the new face of food fraud? Quite possibly.
In fact, as many as one in five staff in the manufacturing industry admit to having been involved in a security breach or loss of sensitive company data, Impero Software research revealed.
We witnessed several key events in which unscrupulous activity made its way into the digital world, including an attack on KP Snacks whereby its systems became compromised by ransomware.

A ransomware attack prevents users from accessing their devices - basically holding your data ransom.
As soon as the company became aware of the breach, it said it enacted its cybersecurity response plan and engaged a leading forensic information technology firm and counsel to assist.
Although the breach occurred in December 2021, it’s also worth noting the Greencore cyberattack, which led to personal information being leaked. After being informed a few months later in 2022, present and former employers were said to have been considering legal action.
During the summer of 2022, Wiltshire Farm Foods, the ready meal supplier, and its parent company Apetito were struck by a cyberattack that caused disruption with deliveries.
Commenting at the time, chair and chief executive at Apetito UK & North America said that its crisis management and IT teams were working “all hours to being critical systems back into operation as soon as possible” but that they expected “significant disruption”.
Generally speaking, the Impero research found that most attacks are a result of insufficient cyber training. The software company revealed that three in 10 want better cyber security training, with as many as 28% saying they do not have the confidence to recognise and report cyber threats at work.
Listen to an interview here with Eric Ervin, 1898 & Co.’s global director for utilities as he discusses how to prepare for potential cyberattacks.
5. Retaining EU law
This year marked the two-year anniversary of “getting Brexit done” and in light of the occasion, saw the UK Government setting out its plans to bring forward the Retained (Revocation and Reform) EU Law Bill.
At the time, Food Manufacture reported on the possibilities (and risks) this ‘freedoms bill’ could bring to the food and drink sector which would see ministers able to replace existing EU regulations and directives with new domestic legislation.
Presently, retained direct EU legislation takes priority over domestic UK legislation passed prior to the end of the Transition Period when they are incompatible. The Bill will reverse this hierarchy, reinstating domestic law as the highest form of law on the UK statute book.
The Bill will ‘sunset’ the majority of retained EU law, so that it expires on 31 December 2023. So without suitable replacements for, or a decision to carry over existing rules, food standards in the UK could be at risk.
As a result, the Food Standards Agency (FSA) has been working through more than 150 pieces of retained EU law so it is able to advise the government on how best to incorporate important rules and safeguard food safety.
“This is a very challenging task,” Susan Jebb, FSA chair said at the time, “and it inevitably means that we will have to deprioritise other important work.”
There have been some prominent headlines since trade discussions began, including debate over US processes, such as chlorinated chicken and hormone-treated cows posing issues to British farming and public health. And more recently concerns were raised over a deal with India possibly sparking an uptick in toxic pesticides in the UK.
The previous PM, Liz Truss, denied claims the UK would be watering down food safety standards in order to reach a deal with the US. But during her short stint, other matters came to the fore; the current asks of our now PM are much more centred around food security than safety.
Indeed, with the cost-of-living crisis presently gripping the UK, Rishi Sunak has been called upon by the industry to support it by cutting red tape.
Sunak was praised by the Food & Drink Federation’s Karen Betts for the work he carried out as Chancellor during the pandemic (i.e. the Eat out to help out scheme), but highlighted the different set of challenges we now face, as trading conditions become tougher still for manufacturers.
The British Frozen Food Federation (BFFF) and Federation of Bakers were in agreement, also urging the PM to act immediately in light of the cost of production crisis or risk many people going hungry this winter.
But there have also been more positive news too, with the reforms giving way for more autonomy in the UK; and we saw the start of such things in March as a list of CBD with credible applications for market authorisation was published. There’s still a way to go in this space and it’s evident things have been slowed due to attention being given (rightly so) to more pressing matters such as feeding the nation this winter.
6. Severe supply chain stress
The stress on supply chains feels never ending; just as we saw the end of lockdowns in the UK, Russia invaded Ukraine, sparking a chain of events which contributed to ingredients shortages, energy price increases and worker shortages.
Of course, one can’t forget the impacts of ‘Brexit’ either – a word that dominated the headlines until Covid – and has swiftly made a return to our newsstands. Together this trio has placed us in an unprecedented ‘permacrisis’ (yes, that’s a real word…at least now it is).
This nasty combination is now threatening the nation’s food security.
More than three quarters of businesses are currently suffering from staff shortages in jobs without high skill hurdles, research from the National Skills Academy for Food and Drink has reported. This is leading to an increase in automation and digitally-controlled production – but there’s a catch, the economic and political uncertainty are undermining business confidence and their ability to invest in new tech and the training needed to employ it.
Meanwhile, the government have unveiled plans to release 45,000 visas for seasonal workers next year in a hope to boost UK horticulture.
Perhaps one of the most severely lacking areas though are qualified engineers. With seemingly glamorous routes such as car engineering to take, the food industry often plays second fiddle. As a sector we need to devise ways of pulling in new talent and letting the young people know why it’s not just a career but a sector they should seriously consider. If we don’t nurture the new generation of minds, this crisis will only get worse.
Commenting on the labour shortage and what could be done to attract new recruits, Geoff Eaton, Chairman of Butcher’s Pet Care, told Food Manufacture: “The Food industry has experienced shortages of people in many areas and especially engineering. We need to work harder to attract engineers into food through providing a more comprehensive package and range of experience and training. This should start from apprenticeships and address all categories of skills.”
To top it all off, we find ourselves in what is being described as the ‘worst ever’ bird flu endemic.
Now, the Environment, Food and Rural Affairs (EFRA) committee has launched a hearing on the latest outbreak which have affected both poultry and eggs. This announcement from EFRA followed news that Waitrose would be investing £2.6 million in the egg supply chain in an effort to boost availability.
In a recent story, Food Manufacture relayed the caution from Kelly Turkeys MD Paul Kelly, who warned urgent action is needed to support Christmas turkey producers. In this piece, he lays out a five-point plan, which you can read here.
Since then, EFRA has also called out the “fundamentally unfair” compensation rules as payment is said to only be made for healthy birds culled by the government vets. Moreover, the longer farmers have to wait for culling, the less compensation they get. As this new strain of avian flu kills birds so quickly however, many of them die in the time between farmers notifying the disease and vets arriving for culling.
7. FMEA finalists announced
Of course, I had to conclude this listicle with the reveal of 2023’s Food Manufacture Excellence Awards (FMEA) finalists!
Despite a turbulent year, there were a bumper number of entries across all the award categories. Now, the best of the best have been shortlisted by a team of expert judges into 16 categories.
The FMEAs are the undisputed, original and best accolades annually recognising corporate and individual excellence in food processing at all levels. Widely regarded in the industry as the gold standard and the ones to win, the awards have continuously evolved to represent the sector’s needs better, and this year is no different.
It’s a fun-filled night and great opportunity to get yourself in the room to network with the finest food and drink manufacturers in the country. The evening provides a totally unique chance to network and talk tactics over a drink with fellow food and drink industry peers.
So, join us as we announce the winners on Thursday 9 February 2023 at London Hilton Bankside. You can still grab tickets here. Hope to see you there!




